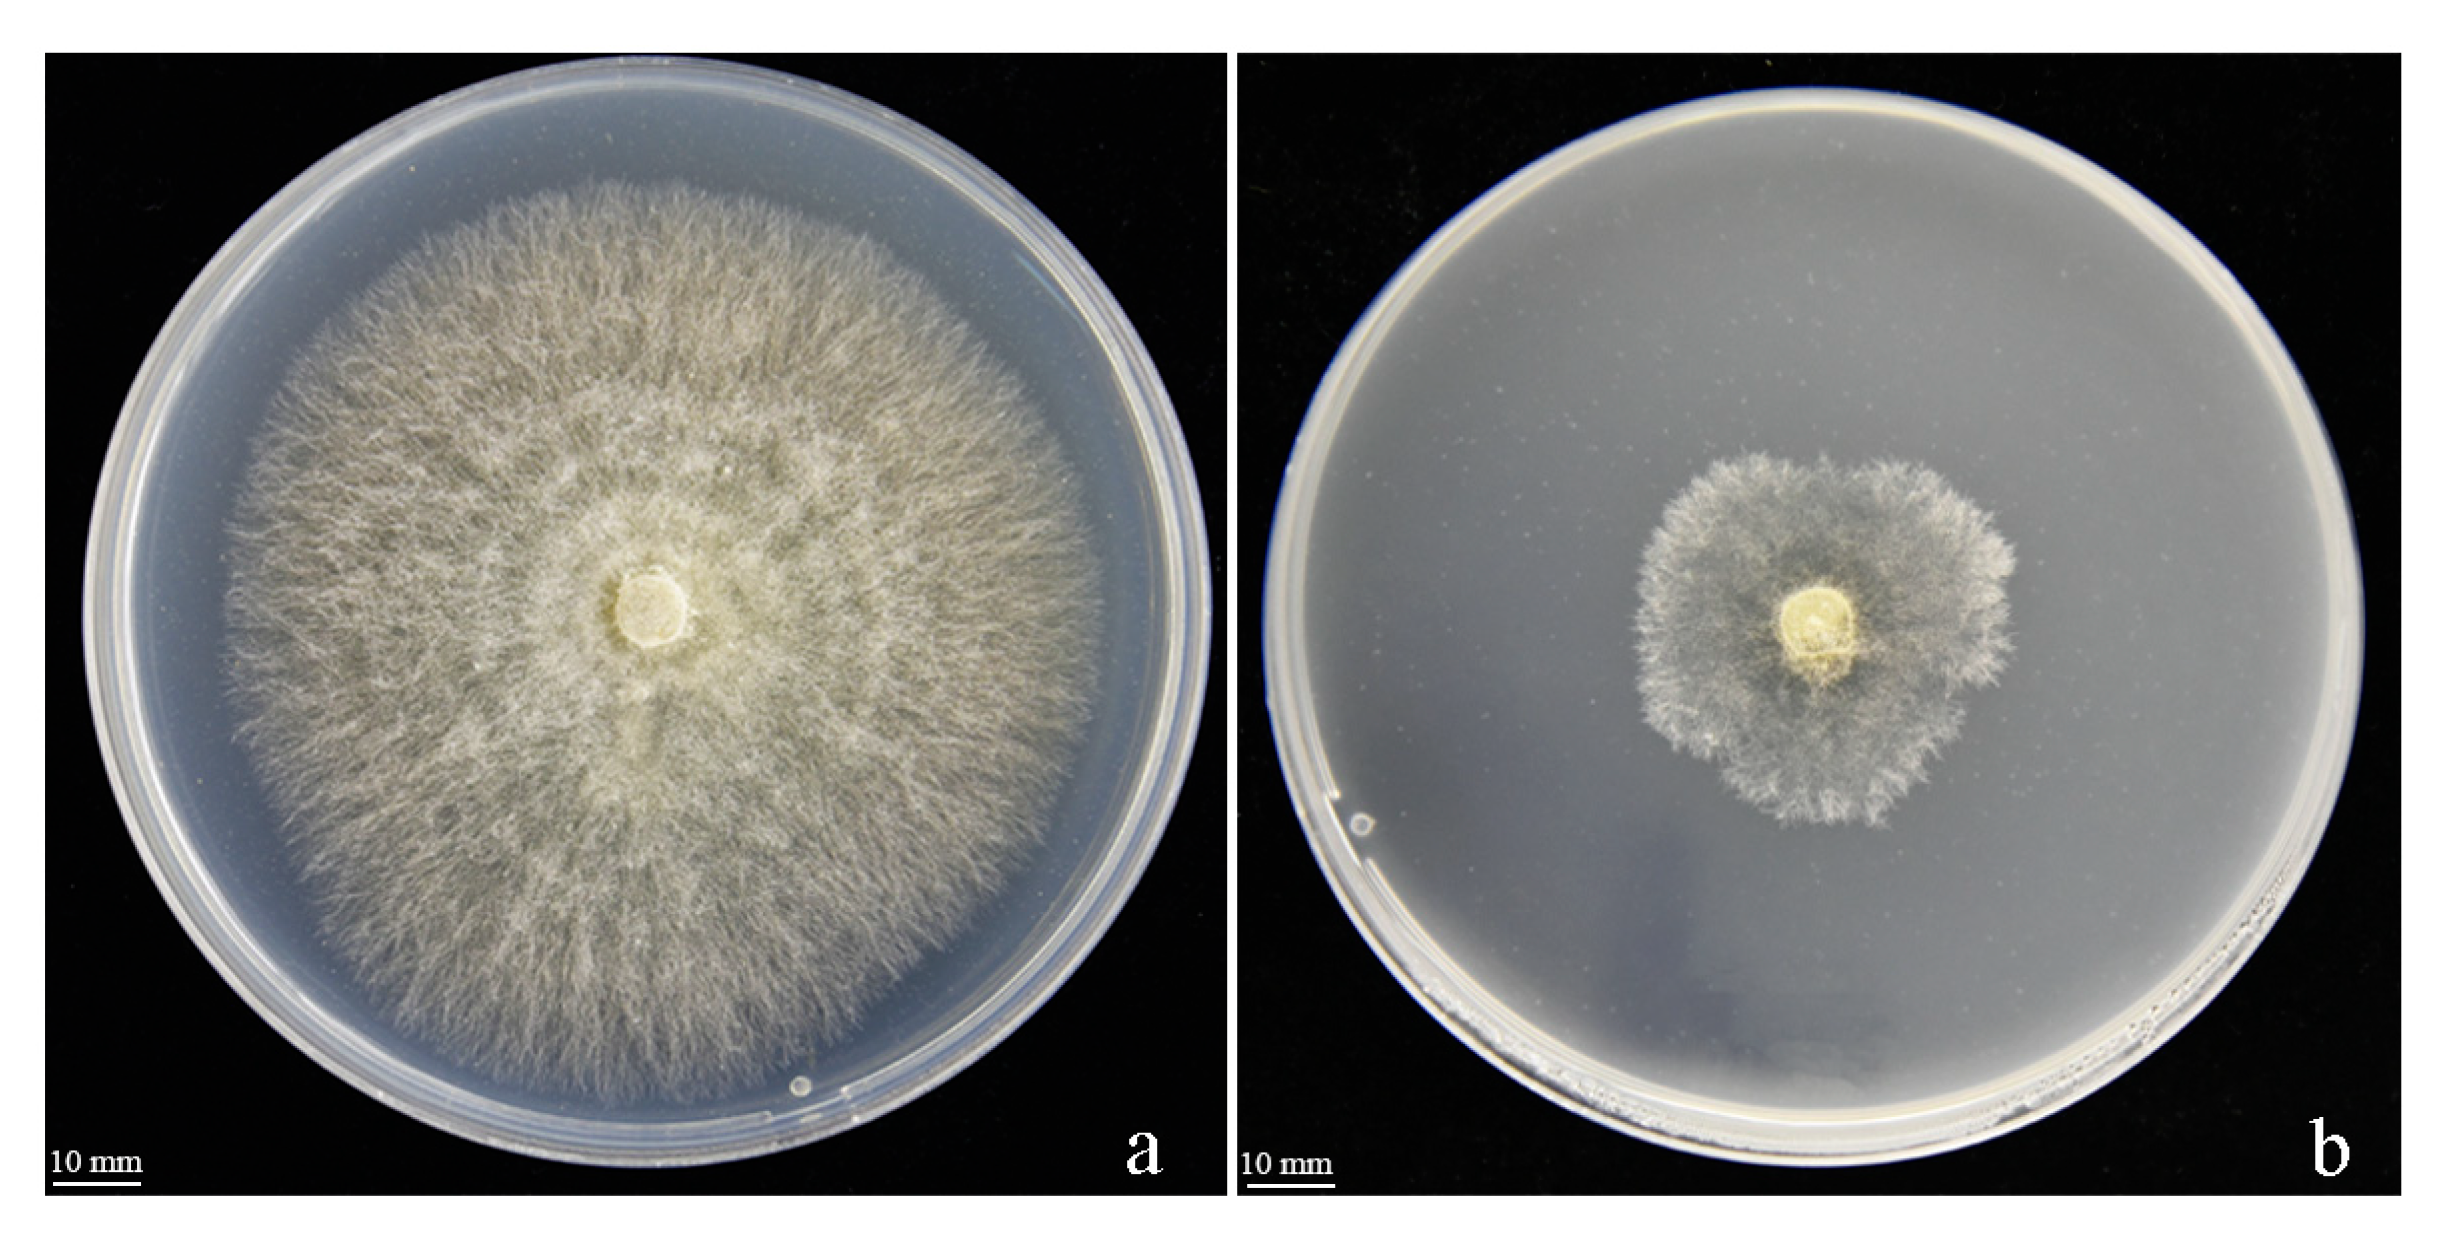
Jof 09 01085 g007

Unveiling the Potential of Bacillus safensis Y246 for Enhanced Suppression of Rhizoctonia solani
Abstract
:1. Introduction
2. Materials and Methods
2.1. Preparation of the Pathogen and Antifungal Strain
2.2. Screening of the Antifungal Strain
2.3. Identification of Antagonistic Strain
2.4. Activity Spectrum of the Strain
2.5. Preparation of Y246 Fermentation Broth and Bacterial Suspension
2.6. Evaluation of BS and BF on R. solani Growth Inhibition
2.7. Aseptic Filtrate Stability
2.8. Effects of Y246 Volatiles on Mycelial Growth
2.9. Scanning Electron Microscope
2.10. Identification of Y246 VOCs with GC-MS
2.11. Statistical Analyses
3. Result and Discussion
3.1. Screening and Identification of Antagonistic Strain
3.2. Antifungal Spectrum of Strain Y426
3.3. Effect of Strain Y246 on the Mycelial Growth of R. solani
3.4. Aseptic Filtrate Stability
3.5. The Effect of VOCs on R. solani
3.6. SEM (Scanning Electron Microscopy)
3.7. Analysis of VOCs by GC-MS
4. Discussion
5. Conclusions
Author Contributions
Funding
Institutional Review Board Statement
Informed Consent Statement
Data Availability Statement
Conflicts of Interest
References
- Chen, Y.H.; Lu, M.H.; Guo, D.S.; Zhai, Y.Y.; Miao, D.; Yue, J.Y.; Yuan, C.H.; Zhao, M.M.; An, D.R. Antifungal Effect of Magnolol and Honokiol from Magnolia officinalis on Alternaria alternata Causing Tobacco Brown Spot. Molecules 2019, 24, 2140. [Google Scholar] [CrossRef] [PubMed]
- Wang, H.C.; Huang, Y.F.; Chen, Q.; Wang, M.S.; Xia, H.Q.; Shang, S.H.; Zhang, C.Q. Anthracnose Caused by Colletotrichum fructicola onTobacco(Nicotiana tabacumin) China. Plant Dis. 2016, 100, 1235. [Google Scholar] [CrossRef]
- Gonzalez, M.; Pujol, M.; Metraux, J.P.; Gonzalez-Garcia, V.; Bolton, M.D.; Borras-Hidalgo, O. Tobacco leaf spot and root rot caused by Rhizoctonia solani Kuhn. Mol. Plant Pathol. 2011, 12, 209–216. [Google Scholar] [CrossRef] [PubMed]
- Sun, M.; Wang, H.; Shi, C.; Li, J.; Cai, L.; Xiang, L.; Liu, T.; Goodwin, P.H.; Chen, X.; Wang, L. Effect of azoxystrobin on tobacco leaf microbial composition and diversity. Front. Plant Sci. 2022, 13, 1101039. [Google Scholar] [CrossRef]
- Chen, X.; Yu, Z.; Sun, Y.; Yang, M.; Jiang, N. Molecular characterization of a novel partitivirus isolated from Rhizoctonia solani. Front. Microbiol. 2022, 13, 978075. [Google Scholar] [CrossRef]
- Groth, D.E.; Bond, J.A. Effects of Cultivars and Fungicides on Rice Sheath Blight, Yield, and Quality. Plant Dis. 2007, 91, 1647–1650. [Google Scholar] [CrossRef] [PubMed]
- Wallon, T.; Sauvageau, A.; Heyden, H.V. Detection and Quantification of Rhizoctonia solani and Rhizoctonia solani AG1-IB Causing the Bottom Rot of Lettuce in Tissues and Soils by Multiplex qPCR. Plants 2020, 10, 57. [Google Scholar] [CrossRef]
- Kuramae, E.E.; Buzeto, A.L.; Ciampi, M.B.; Souza, N.L. Identification of Rhizoctonia solani AG 1-IB in lettuce, AG 4 HG-I in tomato and melon, and AG 4 HG-III in broccoli and spinach, in Brazil. Eur. J. Plant Pathol. 2003, 109, 391–395. [Google Scholar] [CrossRef]
- Xu, S.; Liu, X.; Zhang, J.; Xiao, L.; Zhao, L.; Li, C.; Dong, W.; Yang, G. Morphological and molecular characterization of Rhizoctonia solani AG-3 associated with tobacco target leaf spot in China. J. Basic Microbiol. 2023, 63, 200–209. [Google Scholar] [CrossRef]
- Costa, A.S. Mancha aureolada erequeima do fumo causades porCorti-cium solani. Biologico 1948, 14, 113–114. [Google Scholar]
- Shew, H.D.; Melton, T.A. Tobacco target spot. Plant Dis. 1995, 79, 5–11. [Google Scholar] [CrossRef]
- Nicoletti, R.; Lahoz, E. Target spot of tobacco: A disease of possible introduction in Italy. Tobacco 1995, 3, 1–6. [Google Scholar]
- Shew, H.D.; Main, C.E. Rhizoctonia leaf spot of flue-cured tobacco in North Carolina. Plant Dis. 1985, 69, 901–903. [Google Scholar] [CrossRef]
- Shew, H.D.; Main, C.E. Infection and development of target spot of flue-cured tobacco caused by Thanatephorus cucumeris. Plant Dis. 1990, 74, 1009–1013. [Google Scholar] [CrossRef]
- Cai, J.-H.; Qin, B.-X.; Wei, X.-P.; Huang, J.; Zhou, W.-L.; Lin, B.-S.; Yao, M.; Hu, Z.-Z.; Feng, Z.-K.; Tao, X.-R. Molecular Identification and Characterization of Tomato zonate spot virus in Tobacco in Guangxi, China. Plant Dis. 2011, 95, 1483. [Google Scholar] [CrossRef]
- Cao, Y.; Pi, H.; Chandrangsu, P.; Li, Y.; Wang, Y.; Zhou, H.; Xiong, H.; Helmann, J.D.; Cai, Y. Antagonism of Two Plant-Growth Promoting Bacillus velezensis Isolates Against Ralstonia solanacearum and Fusarium oxysporum. Sci. Rep. 2018, 8, 4360. [Google Scholar] [CrossRef] [PubMed]
- Zhang, C.; Gao, J.; Han, T.; Tian, X.; Wang, F. Integrated control of tobacco black shank by combined use of riboflavin and Bacillus subtilis strain Tpb55. BioControl 2017, 62, 835–845. [Google Scholar] [CrossRef]
- Fan, B.; Wang, C.; Song, X.; Ding, X.; Wu, L.; Wu, H.; Gao, X.; Borriss, R. Bacillus velezensis FZB42 in 2018: The Gram-Positive Model Strain for Plant Growth Promotion and Biocontrol. Front. Microbiol. 2018, 9, 2491. [Google Scholar] [CrossRef] [PubMed]
- Mao, T.; Chen, X.; Ding, H.; Chen, X.; Jiang, X. Pepper growth promotion and Fusarium wilt biocontrol by Trichoderma hamatum MHT1134. Biocontrol Sci. Technol. 2020, 30, 1228–1243. [Google Scholar] [CrossRef]
- Wakelin, S.; Young, S.; Gerard, E.; Mander, C.; O’Callaghan, M. Isolation of root-associated Pseudomonas and Burkholderia spp. with biocontrol and plant growth-promoting traits. Biocontrol Sci. Technol. 2017, 27, 139–143. [Google Scholar] [CrossRef]
- Bae, S.-J.; Mohanta, T.K.; Chung, J.Y.; Ryu, M.; Park, G.; Shim, S.; Hong, S.-B.; Seo, H.; Bae, D.-W.; Bae, I.; et al. Trichoderma metabolites as biological control agents against Phytophthora pathogens. Biol. Control. 2016, 92, 128–138. [Google Scholar] [CrossRef]
- Vurukonda, S.; Giovanardi, D.; Stefani, E. Plant Growth Promoting and Biocontrol Activity of Streptomyces spp. as Endophytes. Int. J. Mol. Sci. 2018, 19, 952. [Google Scholar] [CrossRef]
- Arnaouteli, S.; Matoz-Fernandez, D.A.; Porter, M.; Kalamara, M.; Abbott, J.; MacPhee, C.E.; Davidson, F.A.; Stanley-Wall, N.R. Pulcherrimin formation controls growth arrest of the Bacillus subtilis biofilm. Proc. Natl. Acad. Sci. USA 2019, 116, 13553–13562. [Google Scholar] [CrossRef] [PubMed]
- Kang, S.M.; Radhakrishnan, R.; Lee, I.J. Bacillus amyloliquefaciens subsp. plantarum GR53, a potent biocontrol agent resists Rhizoctonia disease on Chinese cabbage through hormonal and antioxidants regulation. World J. Microbiol. Biotechnol. 2015, 31, 1517–1527. [Google Scholar] [CrossRef] [PubMed]
- Peng, D.; Li, S.; Wang, J.; Chen, C.; Zhou, M. Integrated biological and chemical control of rice sheath blight by Bacillus subtilis NJ-18 and jinggangmycin. Pest Manag. Sci. 2014, 70, 258–263. [Google Scholar] [CrossRef]
- Li, L.; Ma, J.; Li, Y.; Wang, Z.; Gao, T.; Wang, Q. Screening and partial characterization of Bacillus with potential applications in biocontrol of cucumber Fusarium wilt. Crop Prot. 2012, 35, 29–35. [Google Scholar] [CrossRef]
- Liu, L.; Liang, M.; Li, L.; Sun, L.; Xu, Y.; Gao, J.; Wang, L.; Hou, Y.; Huang, S. Synergistic effects of the combined application of Bacillus subtilis H158 and strobilurins for rice sheath blight control. Biol. Control. 2018, 117, 182–187. [Google Scholar] [CrossRef]
- Hu, Y.; Zhao, W.; Li, X.; Feng, J.; Li, C.; Yang, X.; Guo, Q.; Wang, L.; Chen, S.; Li, Y.; et al. Integrated biocontrol of tobacco bacterial wilt by antagonistic bacteria and marigold. Sci. Rep. 2021, 11, 16360. [Google Scholar] [CrossRef] [PubMed]
- Zhang, D.; Yu, S.; Yang, Y.; Zhang, J.; Zhao, D.; Pan, Y.; Fan, S.; Yang, Z.; Zhu, J. Antifungal Effects of Volatiles Produced by Bacillus subtilis Against Alternaria solani in Potato. Front. Microbiol. 2020, 11, 1196. [Google Scholar] [CrossRef]
- Jayakumar, V.; Ramesh Sundar, A.; Viswanathan, R. Biocontrol of Colletotrichum falcatum with volatile metabolites produced by endophytic bacteria and profiling VOCs by headspace SPME coupled with GC–MS. Sugar Tech. 2020, 23, 94–107. [Google Scholar] [CrossRef]
- Xie, S.; Liu, J.; Gu, S.; Chen, X.; Jiang, H.; Ding, T. Antifungal activity of volatile compounds produced by endophytic Bacillus subtilis DZSY21 against Curvularia lunata. Ann. Microbiol. 2020, 70, 2. [Google Scholar] [CrossRef]
- Ling, L.; Zhao, Y.; Tu, Y.; Yang, C.; Ma, W.; Feng, S.; Lu, L.; Zhang, J. The inhibitory effect of volatile organic compounds produced by Bacillus subtilis CL2 on pathogenic fungi of wolfberry. J. Basic Microbiol. 2021, 61, 110–121. [Google Scholar] [CrossRef]
- Gao, H.Y.; Li, P.Z.; Xu, X.X.; Zeng, Q.; Guan, W.Q. Research on volatile organic compounds from Bacillus subtilis CF-3: Biocontrol effects on fruit fungal pathogens and dynamic chanaes during fermentation. Front. Microbioloay 2018, 9, 456–471. [Google Scholar] [CrossRef]
- Asari, S.; Matzen, S.; Petersen, M.A.; Bejai, S.; Meijer, J. Multiple effects of Bacillus amyloliquefaciens volatile compounds: Plant growth promotion and growth inhibition of phytopathogens. FEMS Microbiol. Ecol. 2016, 92, fiw070. [Google Scholar] [CrossRef]
- Morita, T.; Tanaka, I.; Ryuda, N.; Ikari, M.; Ueno, D.; Someya, T. Antifungal spectrum characterization and identification of strong volatile organic compounds produced by Bacillus pumilus TM-R. Heliyon 2019, 5, e01817. [Google Scholar] [CrossRef] [PubMed]
- Yan, F.; Li, C.; Ye, X.; Lian, Y.; Wu, Y.; Wang, X. Antifungal activity of lipopeptides from Bacillus amyloliquefaciens MG3 against Colletotrichum gloeosporioides in loquat fruits. Biol. Control 2020, 146, 104281. [Google Scholar] [CrossRef]
- Ling, L.J.; Jiang, K.L.; Cheng, W.T.; Wang, Y.Y.; Pang, M.M.; Luo, H.; Lu, L.; Gao, K.; Tu, Y.X. Biocontrol of volatile organic compounds obtained from Bacillus subtilis CL2 against Aspergillus flavus in peanuts during storage. Biol. Control 2022, 176, 105094. [Google Scholar] [CrossRef]
- Neelam, S.; Agisha, V.N.; Vibhuti, M.; Aditi, K.; Kesavan, S.; Vibina, V.; Suseelabhai, R.; Santhosh, J.; Aundy, K. Genetic analysis of plant endophytic Pseudomonas putida BP25 and profiling of its antimicrobial volatile organic compounds. Microbiol. Res. 2015, 173, 66–78. [Google Scholar]
- Sun, M.L.; Shi, C.H.; Huang, Y.; Wang, H.C.; Li, J.J.; Cai, L.T.; Luo, F.; Xiang, L.G.; Wang, F. Effect of disease severity on the structure and diversity of the phyllosphere microbial community in tobacco. Front. Microbiol. 2023, 13, 1081576. [Google Scholar] [CrossRef] [PubMed]
- Jacobsen, B.J.; Zidack, N.K.; Larson, B.J. The role of bacillus-based biological control agents in integrated pest management systems:plant diseases. Phytopathology 2004, 94, 1272–1275. [Google Scholar] [CrossRef]
- Zhao, P.Y.; Li, P.Z.; Wu, S.Y.; Zhou, M.S.; Zhi, R.Z.; Gao, H.Y. Volatile organic compounds(VOCs) from Bacillus subtilis CF-3 reduce anthracnose and elicit active defense responses in harvested litchi fruits. AMB Express 2019, 9, 119. [Google Scholar] [CrossRef] [PubMed]
- Luo, L.; Zhao, C.Z.; Wang, E.T.; Ali, R.; Yin, C.Y. Bacillus amyloliquefaciens as an excellent agent for biofertilizer and biocontrol in agriculture: An overview for its mechanisms. Microbiol. Res. 2022, 259, 127016. [Google Scholar] [CrossRef] [PubMed]
- Gamboa-Becerra, R.; Desgarennes, D.; Molina-Torres, J.; Ramírez-Chávez, E.; Kiel-Martínez, A.L.; Carrión, G.; Ortiz-Castro, R. Plant growth-promoting and non-promoting rhizobacteria from avocado trees diferentially emit volatiles that influence growth of Arabidopsis thaliana. Protoplasma 2022, 259, 835–854. [Google Scholar] [CrossRef]
- Cheng, W.L.; Yang, J.Y.; Nie, Q.Y.; Huang, D.; Yu, C.; Zheng, L.Y.; Cai, M.M.; Linda, S.T.; David, M.W.; Yu, Z.N.; et al. Volatile organic compounds from Paenibacillus polymyxa KM2501-1 control Meloidogyne incognita by multiple strategies. Sci. Rep. 2017, 7, 16213. [Google Scholar] [CrossRef]
- Yuan, J.; Raza, W.; Shen, Q.; Huang, Q. Antifungal activity of Bacillus amyloliquefaciens NJN-6 volatile compounds against Fusarium oxysporum. sp. cubense. Appl. Environ. Microbiol. 2012, 78, 5942–5944. [Google Scholar] [CrossRef] [PubMed]
- Zheng, Y.X.; Wang, J.M.; Zhao, W.L.; Cai, X.J.; Xu, Y.L.; Chen, X.L.; Yang, M.; Huang, F.Y.; Yu, L.; He, Y.S. Effect of Bacterial Wilt on Fungal Community Composition in Rhizosphere Soil of Tobaccos in Tropical Yunnan. Plant Pathol. J. 2022, 38, 203. [Google Scholar] [CrossRef] [PubMed]

| Strain Code | Colony Diameter (mm) | Inhibition Rate (%) |
|---|---|---|
| Control | 90.00 | / |
| L154 | 32.33 ± 1.16 | 64.07 ± 1.29 |
| L545 | 35.33 ± 3.83 | 60.74 ± 4.26 |
| L1433 | 41.33 ± 3.56 | 54.07 ± 3.96 |
| Y246 | 21.33 ± 1.48 | 76.30 ± 1.64 |
| Y248 | 25.15 ± 0.59 | 72.06 ± 0.66 |
| Y2433 | 24.65 ± 2.15 | 72.61 ± 2.39 |
| Y2431 | 33.83 ± 1.20 | 62.41 ± 1.33 |
| Disease | Pathogen | Inhibition Rate of Y246 (%) |
|---|---|---|
| Tobacco brown spot | Alternaria alternata | 62.96 ± 0.02 |
| Kiwifruit soft rot | Phomopsis. sp. | 41.54 ± 0.54 |
| Banana anthracnose | Gloeosporium musarum | 40.04 ± 0.54 |
| Kiwifruit black spot | Alternaria alternata | 46.23 ± 0.75 |
| Pomegranate leaf spot | Dwiroopa punicae | 37.92 ± 0.14 |
| Anthracnose of passion fruit | Colletotrichum karstii | 44.32 ± 0.81 |
| Fruit rot of apple | Botryosphaeria auasmontanum | 36.11 ± 0.53 |
| Tomato gray mold | Botrytis cinerea | 40.08 ± 0.60 |
| Treatment | Colony Diameter (mm) | Inhibition Rate (%) |
|---|---|---|
| Fermentation broth | 25.78 ± 0.42 | 66.59 ± 0.54 |
| Bacterial suspension | 27.97 ± 2.61 | 63.75 ± 3.39 |
| Treatment | Colony Diameter (mm) | Inhibition Rate (%) |
|---|---|---|
| CK | 72.63 ± 0.21 | / |
| Y246 | 21.65 ± 0.69 | 70.19 ± 0.94 |
| Compounds ID | Name | Molecular Formula | Retention time (min) |
|---|---|---|---|
| Com_11 | Methyl Isobutyl Ketone | C7H16O | 5.5 |
| Com_15 | 2-Butanone | C4H8O | 3.29 |
| Com_24 | 3-Hydroxypropionic acid | C3H6O3 | 35.77 |
| Com_27 | Butanoic acid, 3-methyl- | C5H10O2 | 24.40 |
| Com_30 | 1-Nonanol | C9H22O | 14.26 |
| Com_51 | Dodecane | C12H26 | 11.42 |
| Com_62 | 2-Nonanone | C9H18O | 18.80 |
| Com_68 | 2,3-Butanedione | C4H6O2 | 4.73 |
| Com_94 | Benzaldehyde | C7H6O | 20.64 |
| Com_97 | 2-Decanol | C10H22O | 20.33 |
| Com_101 | 2-Heptanone | C7H14O | 11.01 |
| Com_104 | 1-Butanol | C4H10O | 10.33 |
| Com_110 | 2-Ethyl-1-hexanol | C8H18O | 7.91 |
| Com_120 | Pyrazine, methyl- | C5H6N2 | 13.71 |
| Com_133 | Dibutyl phthalate | C16H22O4 | 42.80 |
| Com_143 | 1-Butanol, 3-methyl- | C7H14O2 | 12.20 |
| Com_147 | 2,3-Butanediol | C4H10O2 | 19.02 |
| Com_148 | Butyrolactone | C24H24O8 | 23.20 |
| Com_160 | Ethyl Acetate | C4H8O2 | 3.13 |
| Com_167 | Propanoic acid, 2-methyl- | C4H8O2 | 21.98 |
| Com_172 | Butanoic acid, 2-methyl- | C5HO2 | 24.38 |
| Com_175 | 2-Octanol | C8H18O | 18.29 |
| Com_179 | Furfural | C5H4O2 | 19.15 |
| Com_181 | Acetoin | C4H8O2 | 14.29 |
| Com_183 | Disulfide, dimethyl | C2H6S2 | 7.39 |
| Com_195 | Tridecane | C13H28 | 14.70 |
| Com_198 | 2-Decanone | C10H20O | 19.10 |
| Com_201 | Hexanal | C6H12O | 7.76 |
| Com_210 | Propanoic acid | CH3CH2COOH | 21.23 |
| Com_215 | Ethanol | C2H6O | 3.93 |
| Com_219 | Acetic acid | C2H4O2 | 18.98 |
| Com_237 | 2-Octanone | C8H16O | 14.23 |
| Com_242 | Pyrazine, 2,5-dimethyl- | C6H8N2 | 15.41 |
| Com_243 | Heptadecane | C17H36 | 25.13 |
Disclaimer/Publisher’s Note: The statements, opinions and data contained in all publications are solely those of the individual author(s) and contributor(s) and not of MDPI and/or the editor(s). MDPI and/or the editor(s) disclaim responsibility for any injury to people or property resulting from any ideas, methods, instructions or products referred to in the content. |
© 2023 by the authors. Licensee MDPI, Basel, Switzerland. This article is an open access article distributed under the terms and conditions of the Creative Commons Attribution (CC BY) license (https://creativecommons.org/licenses/by/4.0/).
Share and Cite
Zhu, X.-C.; Xu, S.-G.; Wang, Y.-R.; Zou, M.-T.; Mridha, M.A.U.; Javed, K.; Wang, Y. Unveiling the Potential of Bacillus safensis Y246 for Enhanced Suppression of Rhizoctonia solani. J. Fungi 2023, 9, 1085. https://doi.org/10.3390/jof9111085
Zhu X-C, Xu S-G, Wang Y-R, Zou M-T, Mridha MAU, Javed K, Wang Y. Unveiling the Potential of Bacillus safensis Y246 for Enhanced Suppression of Rhizoctonia solani. Journal of Fungi. 2023; 9(11):1085. https://doi.org/10.3390/jof9111085
Chicago/Turabian StyleZhu, Xing-Cheng, Shu-Gang Xu, Yu-Ru Wang, Meng-Ting Zou, Mohammed Amin Uddin Mridha, Khadija Javed, and Yong Wang. 2023. "Unveiling the Potential of Bacillus safensis Y246 for Enhanced Suppression of Rhizoctonia solani" Journal of Fungi 9, no. 11: 1085. https://doi.org/10.3390/jof9111085
APA StyleZhu, X.-C., Xu, S.-G., Wang, Y.-R., Zou, M.-T., Mridha, M. A. U., Javed, K., & Wang, Y. (2023). Unveiling the Potential of Bacillus safensis Y246 for Enhanced Suppression of Rhizoctonia solani. Journal of Fungi, 9(11), 1085. https://doi.org/10.3390/jof9111085








